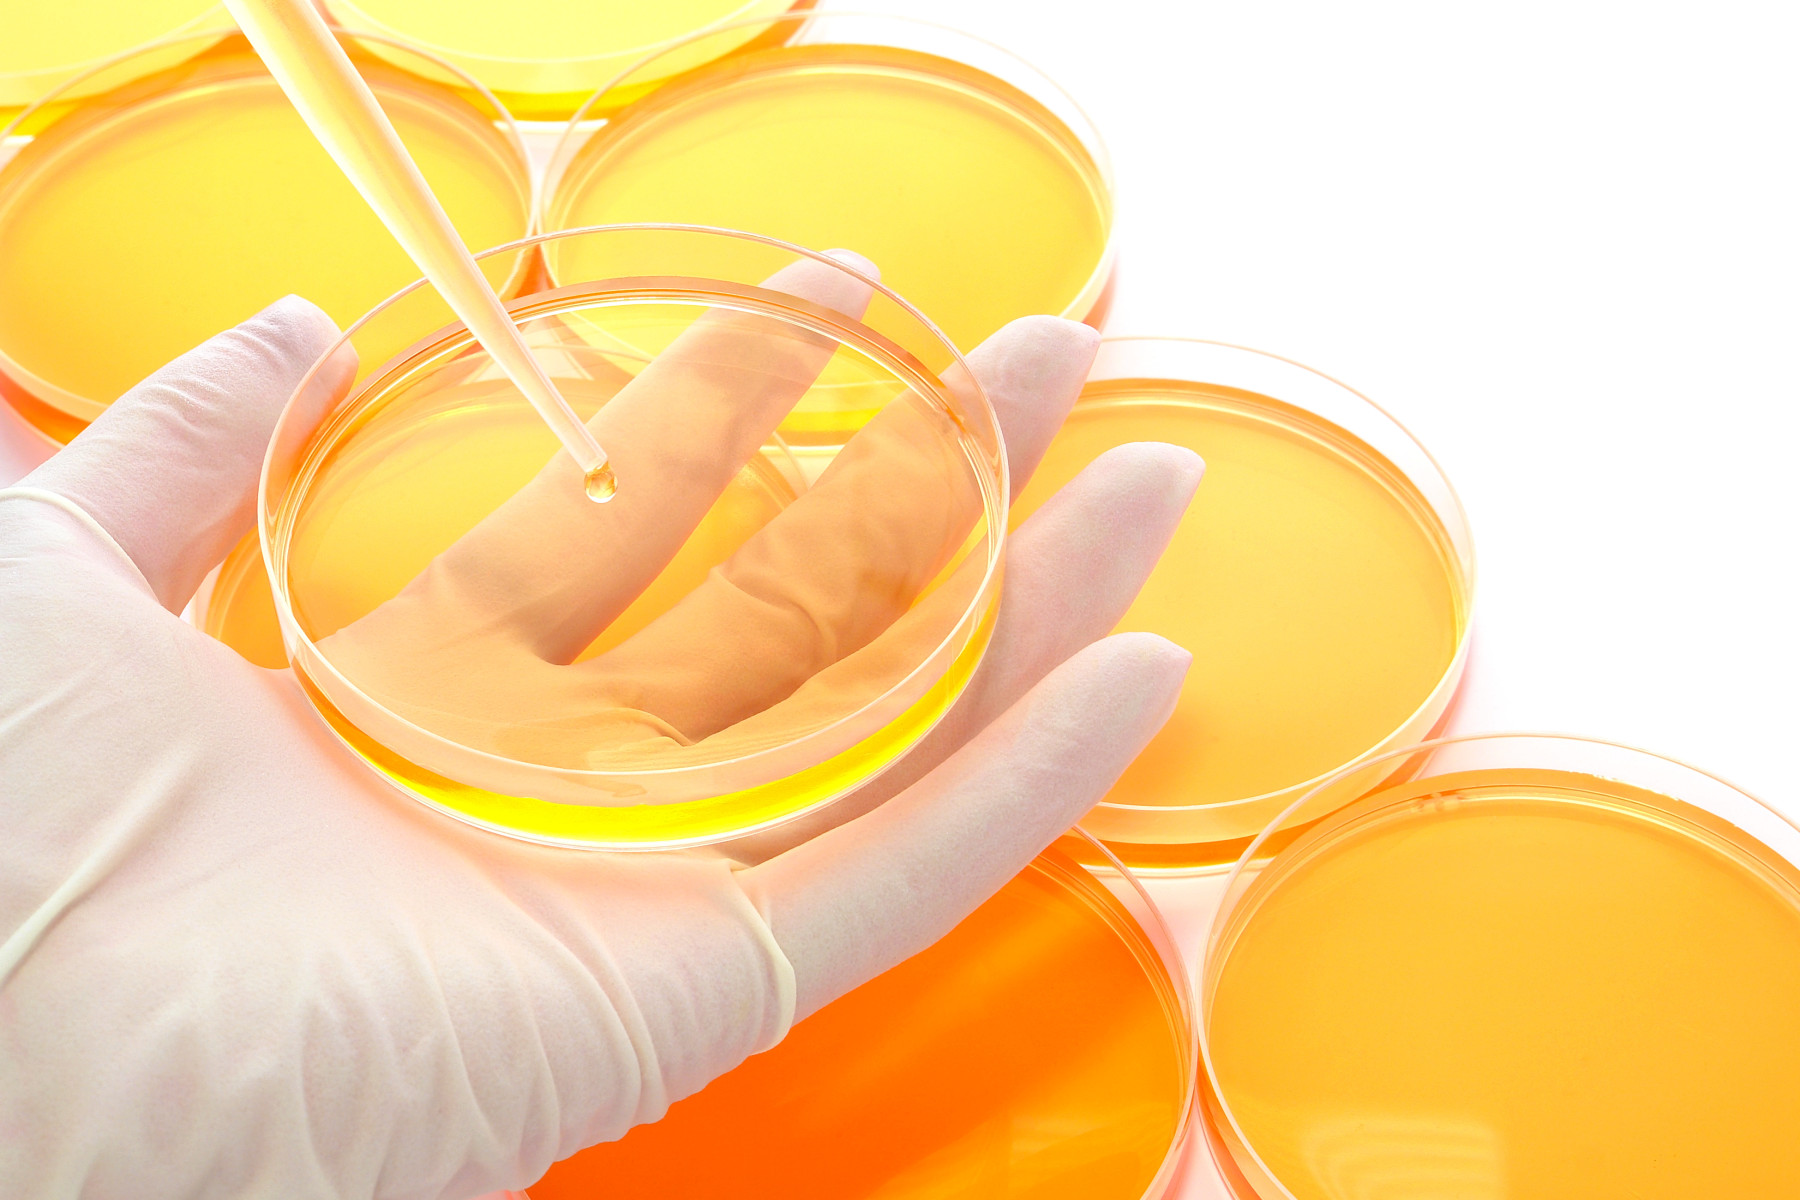

Peak Proteins is a contract research organisation specializing in protein production, characterization, and structure determination. Founded in 2014 by former AstraZeneca scientists, the company offers services including protein expression and purification, protein crystallography, structure determination, and mass spectrometry. These services support drug discovery and research applications by providing tailored protein reagents and structural insights
Sygnature Discovery, a Nottingham-based integrated discovery and preclinical solutions provider, acquired Peak Proteins Ltd in April 2022 to enhance its drug discovery capabilities. This acquisition followed a longstanding partnership between the two companies and aimed to integrate Peak Proteins' expertise in protein production and structural determination into Sygnature's services.

.png)